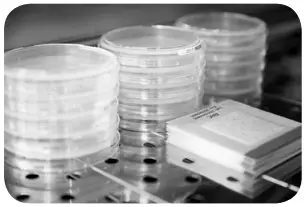
impex MC Media Pad Rapid Aerobic Count - incubate test plate

Instruction Manual
MCMedia Pad Rapid Aerobic Count
Convenient culture media for rapid enumeration of aerobic microbial contamination
Application
For hygiene control, it is important to determine the microbial count in food and beverage products. MC-Media Pad Rapid Aerobic Count is intended to determine the total aerobic count using a special medium composition and unique redox indicator dyes for not only standard but also rapid enumeration.
MC-Media Pad pre-sterilized, ready-to-use dry culture devices simplify testing and minimize the quantity of waste. MC-Media Pad is composed of a unique adhesive sheet, a test pad coated with medium and water absorption polymer, and a transparent cover film.
Test Principles
MC-Media Pads are coated with selective medium and chromogenic substrate for specific detection. Once the liquid sample is inoculated onto the test pad, the sample diffuses through the whole pad by capillary action.
The medium re-constitutes automatically. If aerobic bacteria are present, they grow as red-colored colonies on the test pad.
Method Validation
AOAC Performance Tested MethodSM study (Cer. No. 091702)
MC-Media Pad Rapid Aerobic Count was shown to be equivalent to USDA FSIS MLG 3.02 for raw chicken breast and raw ground pork; to Standard Methods for the Examination of Dairy Products Chapter 6 for cream cheese and yogurt drink; to AOAC OMA 966.23 for parsley, vegetable juice, prawns, tuna pate, sandwiches, and pasta salad; and to ISO 4833:2013 for raw chicken breast, raw ground pork, cream cheese, yogurt drink, parsley, vegetable juice, prawns, tuna pate, sandwiches, and pasta salad.
Contents and Storage
100 pads (4×25 pads); catalog number 1323020001
This kit should be stored between 2-15°C. (Refrigerated)
Materials Required but not Provided
- Incubator (30 or 35±1°C)
- Stomacher or Blender
- Sampling bag (Recommended for Stomacher; a bag with a filter to eliminate food debris)
- Pipette or Pipettor and pipette tips
- Maximum Recovery Diluent (MRD), Butterfield’s Phosphate Buffer (BPB), Buffered Peptone Water (BPW), 2% sodium citrate, according to EN ISO 6887. Phosphate Buffered Saline (PBS) or Saline are available (not included in AOAC-PTM certification).
Sample Preparation
For solid food samples
Homogenize a 10 or 50g portion in the 9-fold volume of MRD, BPB, or appropriate diluents with a stomacher or blender. If necessary, make a 10-fold serial dilution. For dairy products homogenize the 11g test portion in 99 mL of 2% sodium citrate at 40-45 °C. If necessary, add 11 mL of homogenate into 99 mL BPB for serial dilution.
For liquid samples
Samples can be applied directly or diluted with MRD or appropriate diluents as for solid samples. If necessary, the pH of the sample should be adjusted to neutral (pH 7.0 ±0.2). For yogurt drink, homogenize 11 mL test portion in 99 mL of BPB. If necessary, add 11 mL of homogenate into 99mL BPB for serial dilution.
Test Procedure
Contents General Operation
- Open the aluminum bag, and remove MC-Media Pad. If necessary, write information on the cover film.
- Lift the transparent cover film and pipette 1.0 mL of sample solution onto the test pad. (It is recommended to lift the cover film diagonally for easy and secure re-sealing.)


- Close the cover film and lightly press the edges of the film to seal.

- For standard usage, incubate the test plate at 35±1 °C for 48 ± 2 hours (according to USDA FSIS, AOAC OMA 966.23, Standard Methods for Examination of Dairy Products) or for alternative usage at 30±1 °C for 72± 3 hours (acc. EN ISO 4833). For rapid usage, incubate the test plate at 35±1 °C for 24±2 hours. The standard usage is applicable for all food products. For food products that contain large amounts of lactic acid bacteria (e.g. Lactobacillus sp.) and psychrophilic bacteria (e.g. Pseudomonas sp.) rapid usage may not be applicable.

- Re-seal the opened bags and store them at 2-15°C for up to 4 weeks.

Interpretation

Count all reddish-colored colonies. Certain bacteria (in particular Bacillus species strains) may form diffuse and fuzzy round shapes. In that case, dark-colored points should be counted as colonies. For large numbers of colonies, colony counts can be estimated by counting colonies in one grid square and multiplying by 20.
If more than 10 4 microbes are grown, the entire test pad may appear as stained, and it may appear that no individual colonies were formed. If this is the case, dilute the sample further and re-test. If necessary, a target colony can be picked up with a sterile needle from the test pad for further analysis.
Precautions
- The test is designed for use by quality control personnel and others familiar with testing samples potentially contaminated with aerobic microbes
- Use personal protective equipment such as gloves, laboratory coat, and eye protection. Treat samples and inoculated devices as potentially biohazardous
- Read this instruction manual carefully before use
- After opening the aluminum bag, unused pads should be stored in the aluminum bag sealed with tape, and kept in a cool (2-15 °C) environment. After opening, use all pads within 1 month
- Do not expose unused pads to sunlight or ultraviolet light.
- Do not use a discolored or damaged pad
- A wrinkle on the test pad should not affect the detection
- Small fragments of fabric on or around the test pad should not affect the detection
- Do not use the pads after the expiration date. The quality of an expired pad is not warranted
- The measurement range is less than 300 CFU/pad. If more than 300 CFU/pad is counted, further dilution is recommended
- The rapid mode test is not suitable for all foods. Therefore, suitability should be verified using your own samples before applying
- The nature of the food (high viscosity food or food dye) may affect test usage or results. In that case, the causes need to be eliminated by dilution or other means
- The used kit must be decontaminated by autoclaving or boiling and disposed of according to local regulations for waste
Impex Produkter AS
Gamle Drammensvei 107
1363 Høvik
www.impex.no
[email protected]
Tel.: 22 32 77 20